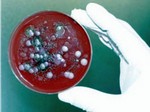

В США образцы сибирской язвы отправили не по адресу | |
|
Живые споры сибирской язвы оказались на крупнейшей в Южной Корее базе ВВС США
Американские военные по ошибке направили образцы живых спор сибирской язвы в Южную Корею. Эту информацию уже подтвердили в Пентагоне. Американские военные по ошибке направили образцы живых спор сибирской язвы в Южную Корею. Эту информацию уже подтвердили в Пентагоне. Живые споры сибирской язвы попали на крупнейшую в Южной Корее базу ВВС США Осан. На южнокорейской базе эти образцы уничтожили сразу же после того, как стало известно, что речь идет о живых спорах. В соответствии с инструкцией, споры сибирской язвы должны перевозиться лишь в умерщвленном виде, пишет Сегодня. Предположительно, отправили их из военной лаборатории при полигоне Дагуэй в штате Юта, где проходят учения по защите от химического и биологического оружия. Другие материалы: Преимущества электронных денег Как избежать ошибок при обустройстве детской комнаты Создан уникальный гриль, работающий на солнечной энергии Henes разработала уникальный детский электромобиль Broon Представляющие опасность живые споры болезни также были отправлены в лаборатории девяти американских штатов, включая Мэриленд. Сейчас в этих лабораториях проходят проверки. В них принимают участие специалисты из Центров по контролю и профилактике заболеваний. При этом в Пентагоне утверждают: никакой угрозы здоровью людей нет, но четыре человека из лаборатории в Мэриленде, куда попал опасный груз, в целях предосторожности начали принимать лекарства. | |
|
28.05.2015 в 18:07 1222 Мир | |
| Комментариев: 0 | |
Войдите, чтобы оставить комментарий.